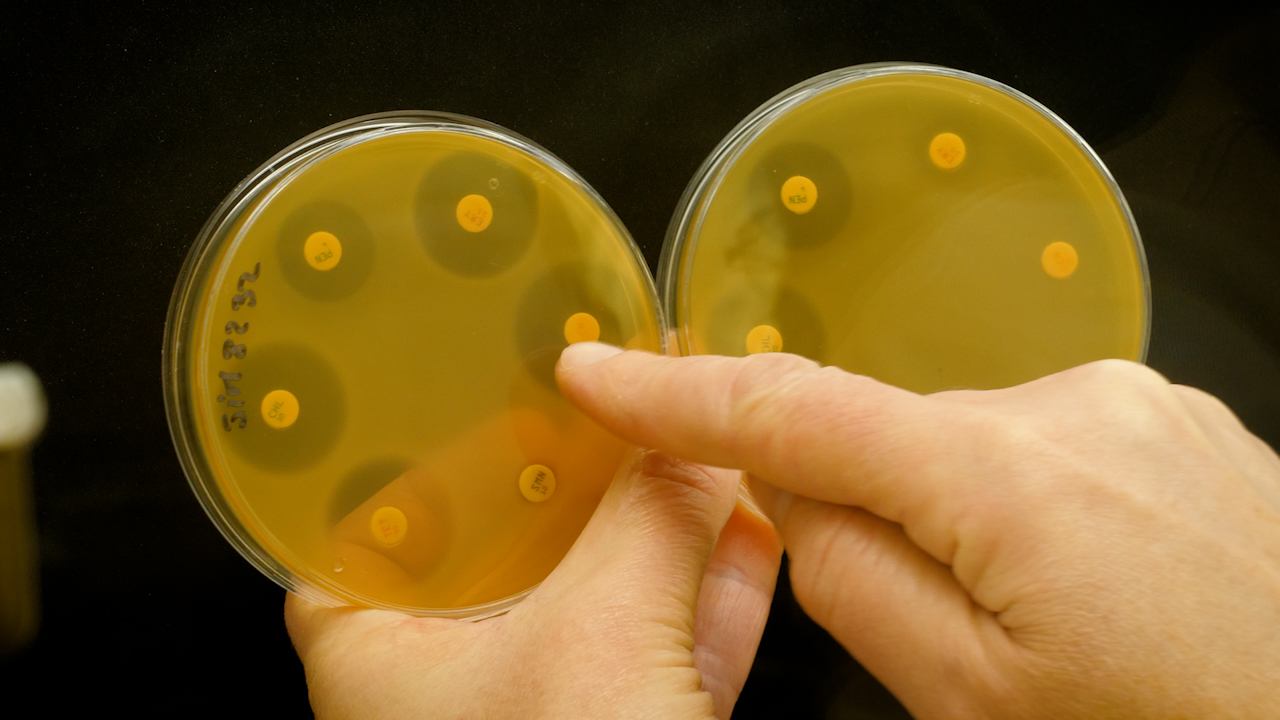

Comprendre les mécanismes qui rendent les bactéries résistantes aux antibiotiques, c’est l’une des missions des chercheurs du laboratoire DynAMic de l’Université de Lorraine. Leur objectif : limiter la dissémination des gènes de résistance dans les bactéries.
Ce film réalisé par Jérôme Didelot en décembre 2020 est produit par l’Université de Lorraine (sous-direction des usages du numérique / production audiovisuelle et multimédia) grâce au soutien de son Conseil scientifique et avec les interventions de Badreddine Douzi, Sophie Payot-Lacroix, Nicolas Soler.